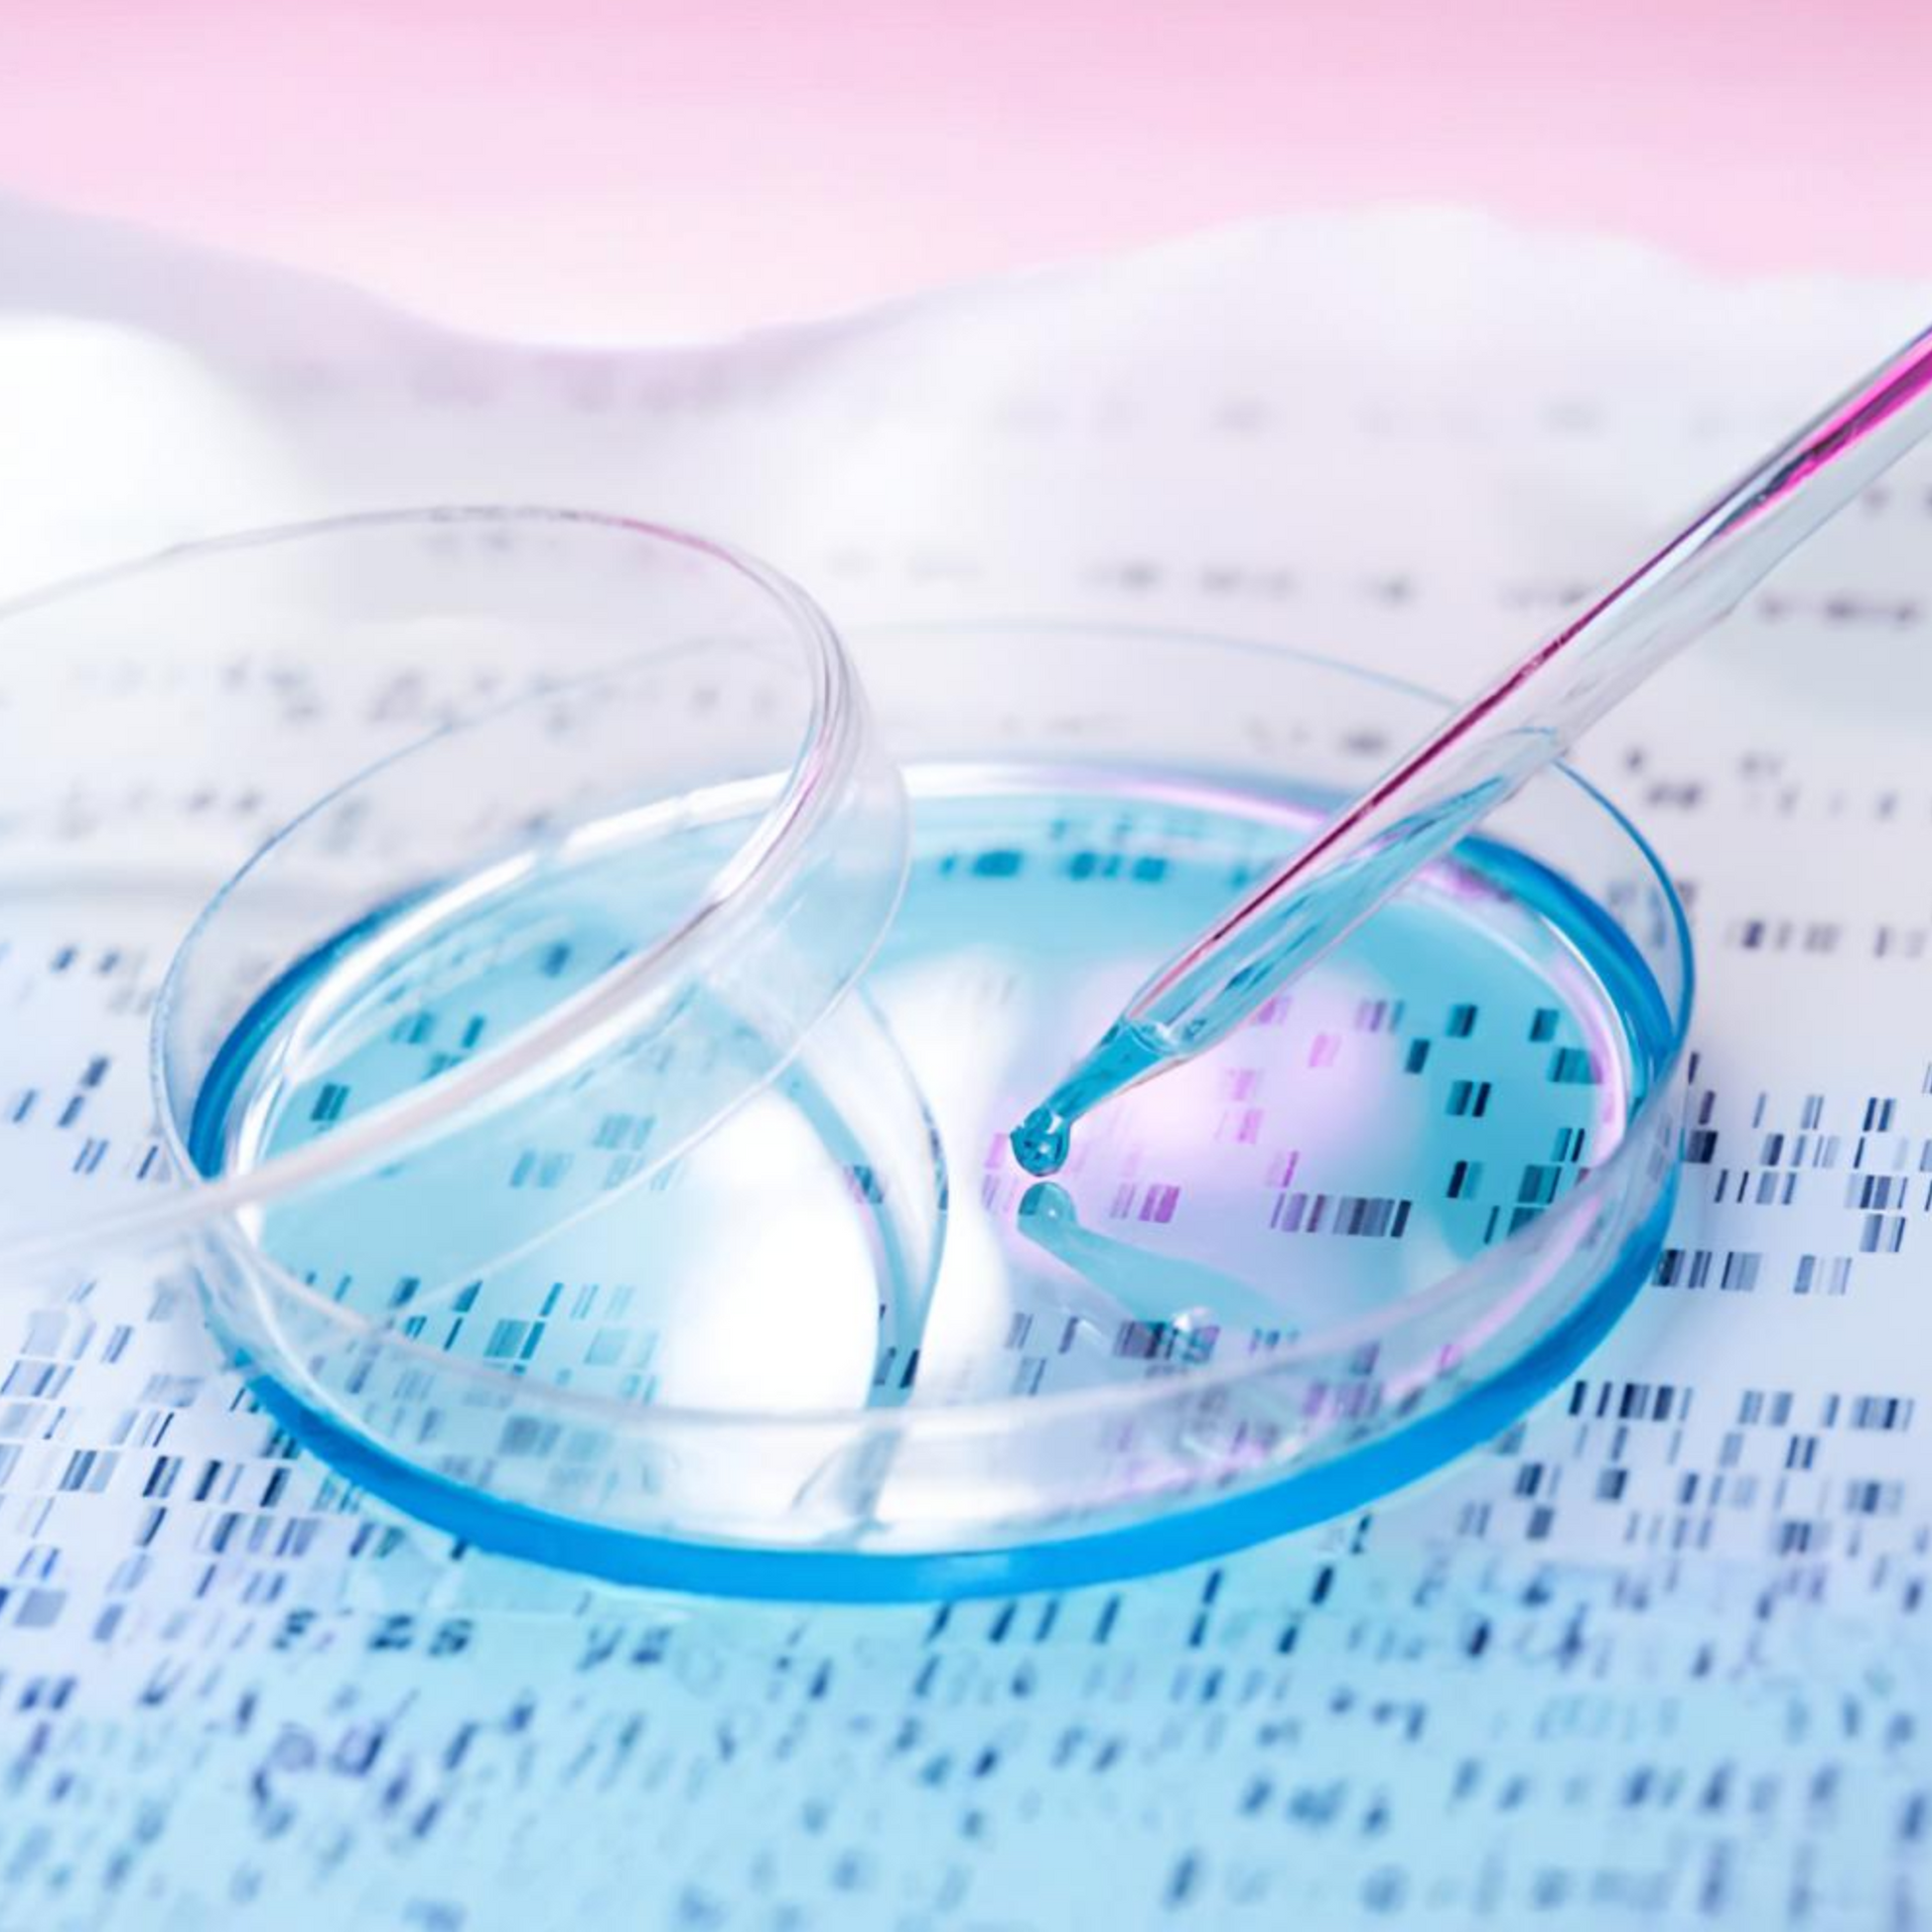
Buy Dry Ice Petri dish

Dry Ice for Pathology & Biomedical (12mm Nuggets)
Dry Ice for Pathology & Biomedical (12mm Nuggets)
Description
Our dry ice solutions for pathology are designed to ensure safe, reliable cooling for the transport and preservation of biological samples. The dry ice maintains low temperatures essential for sample integrity, making it ideal for labs, hospitals, and diagnostic centers. With secure packaging, our dry ice supports efficient handling and minimizes sublimation during transit. Rely on us for trusted cold chain management in pathology applications.
- Order before 11am for next day delivery. If placing an order over the weekend our next available delivery will be for Tuesday. Please email us sales@dryicedirect.com.au for any urgent requests
- Delivery to Metro areas only – 25km ring of the CBD the next business day between 8am – 5pm.
- 1 Poly box (airline approved)
- ❄️ Dry ice will sublimate (evaporate) at ~30% per day; please order quantity with this in mind.
- Polybox small (up to 10 kilos): 40 × 24 × 25 cm
- Polybox large (up to 20 kilos): 58 × 38 × 25 cm
| Order Amount | Next day delivered price (inclusive of GST) |
|---|---|
| 5 kilos | $95.00 |
| 10 kilos | $130.00 |
| 20 kilos | $160.00 |
Block ice - for fridge/ freezers
Block ice - for fridge/ freezers
- drop down options
- 5 kilo minimum $75.00 2 x (2.5 kilo blocks)
- 10 kilos $100.00 2 x 5kg blocks
- 20 kilos $150.00 AUD 4 x 5kg blocks
Larger quantity required?
Larger quantity required?
Dry Ice Direct is the go-to dry ice supplier in Metropolitan areas, serving companies and organizations of all sizes with great service, on-time deliveries and top quality products.
Commercial Uses for Dry Ice
Dry Ice Direct provides dry ice to customers across many industries, for use in a multiple commercial application:
1. Food distribution (frozen or refrigerated)
2. Shipping of perishable items
3. Research & laboratory uses / Biomedical products shipping
4. Restaurants
5. Event Planners
Reach out to the team to learn more about our services and pricing.
Tell us more about your business or organization and how you’re planning to use dry ice.
Email: sales@dryicedirect.com.au
Contact us directly
Contact us directly
Reach out to the team to learn more about our services and pricing. Tell us more about your business or organization and how you’re planning to use dry ice. Email us and we will endeavour to respond within 2 business hours:
Email: sales@dryicedirect.com.au
Please read our FAQs & How to Guides first as most questions are answered here.
Brand Value Statement
At Dry Ice Direct, we are dedicated to providing premium dry ice solutions to our customers, our partners and our community.
Biodegradable - Eco Friendly
Reduce Carbon Footprint
Recycled Waste Reduction
Non-Toxic & Sustainable
Solid Carbon dioxide
Safety instructions
Please ensure you familiarize yourself with our safety instructions.

Sublimation and Storage
Our dry ice will sublimate (turn back to a gas) at approximately 30% within a 24 hr period.

Handling Dry Ice
Always handle dry ice with protective gloves. If you don't have gloves, you can use a towel.
For Transporting
If driving with your dry ice poly box, keep the windows down or keep the box in the boot.

Need Help? Explore Our FAQs
What is Dry Ice
What is Dry Ice
Dry ice is a name that is applied to compressed carbon dioxide, “snow.”
Does it Melt
Does it Melt
No. Dry ice goes through a process called “sublimation” in which a solid substance skips the liquid state and changes directly into a gaseous state.
Dry Ice Safety - Important
Dry Ice Safety - Important
Dry ice is extremely cold, cold enough to freeze skin cells and cause an injury similar to a burn. Always handle dry ice with protective gloves. If you don't have gloves, you could also use a towel or oven mitt -- anything that acts as a buffer between your skin and the dry ice.
Supervision: Children MUST be supervised by a responsible adult. Never leave dry ice within reach of anyone under the age of 18.
Contact: Do not swallow, or put dry ice in your mouth. Do not put dry ice in anyone’s clothing for fun. Potentially severe frostbite may occur as a result of prolonged contact with the skin.
Containers/Jars: Do not place dry ice inside an airtight container. Sublimed vapour will increase the interior pressure and will rupture the container.
Transporting your dry ice: Place a thick layer of cardboard, Styrofoam or similar separator between food and liquid products which need to be chilled. Food and liquid products in containers will freeze when their container is placed in contact with dry ice over a short period of time.
Ventilation
Ventilation
Dry ice gives off CO2 (carbon dioxide) gas into the air, which can be dangerous within a confined space, such as a car, van, or room. If dry ice has been present in a confined space for more than 10 minutes, open the doors and windows before entering the space. Otherwise, you will experience difficulty breathing, light-headedness and potential injury or death.
Leave the area immediately if you start to breathe quickly or have any difficulty breathing!